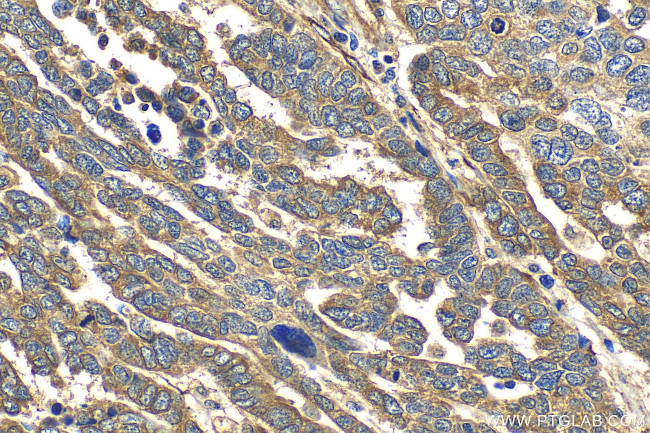
FKBP10/FKBP65 Antibody in Immunohistochemistry (Paraffin) (IHC (P))

Search
Proteintech
FKBP10/FKBP65 Recombinant Rabbit Monoclonal Antibody (S94)
{{$productOrderCtrl.translations['antibody.pdp.commerceCard.promotion.promotions']}}
{{$productOrderCtrl.translations['antibody.pdp.commerceCard.promotion.viewpromo']}}
{{$productOrderCtrl.translations['antibody.pdp.commerceCard.promotion.promocode']}}: {{promo.promoCode}} {{promo.promoTitle}} {{promo.promoDescription}}. {{$productOrderCtrl.translations['antibody.pdp.commerceCard.promotion.learnmore']}}
产品信息
81567-1-RR
种属反应
宿主/亚型
Expression System
分类
类型
克隆号
抗原
偶联物
形式
纯化类型
保存液
内含物
保存条件
运输条件
产品详细信息
Immunogen sequence: PFLAYGEKGY GTVIPPQASL VFHVLLIDVH NPKDAVQLET LELPPGCVRR AGAGDFMRYH YNGSLMDGTL FDSSYSRNHT YNTYIGQGYI IPGMDQGLQG ACMGERRRIT IPPHLAYGEN GTGDKIPGSA VLIFNVHVID FHNPADVVEI RTLSRPSETC NETTKLGDFV RYHYNCSLLD GTQLFTSHDY GAPQEATLGA NKVIEGLDTG LQGMCVGERR QLIVPPHLAH GESGARGVPG SAVLLFEVEL VSREDGLPTG YLFVWHKDPP ANLFEDMDLN KDGEVPPEEF STFIKAQVSE GKGRLMPGQD PEKTIGDMFQ NQDRNQDGKI TVDELKLKSD EDEERVHEEL
靶标信息
MAF acts as a transcriptional activator or repressor. The protein is involved in embryonic lens fiber cell development.
仅用于科研。不用于诊断过程。未经明确授权不得转售。
篇参考文献 (0)
生物信息学
蛋白别名: 65 kDa FK506-binding protein; 65 kDa FKBP; FK506 binding protein 10, 65 kDa; FK506-binding protein 10; FKBP-10; FKBP-65; Immunophilin FKBP65; Peptidyl-prolyl cis-trans isomerase FKBP10; PPIase FKBP10; Rotamase
基因别名: BRKS1; FKBP10; FKBP65; hFKBP65; OI11; OI6; PPIASE; PSEC0056
UniProt ID: (Human) Q96AY3
Entrez Gene ID: (Human) 60681